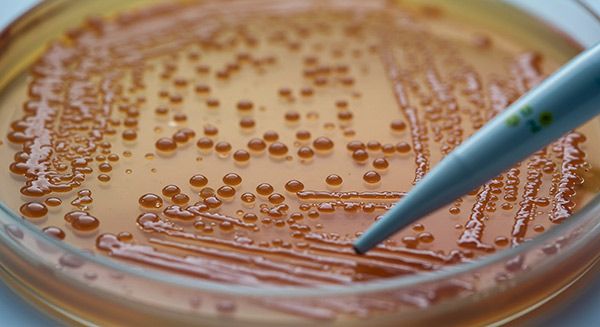
A petri dish in a lab showing bacterial colonies growing, indicating water contamination from a failed test

The Independent Guide to Pure Water
In-Depth Analysis.
Proven DIY Guides.
Built on a Decade of Hands-On Experience
I’m Aleksandr Pavlov. My journey into water purification didn’t start in a salesroom—it started with a frustrating water problem in my own home, just like the one you might be facing today. For over a decade, I’ve been in the trenches: installing, troubleshooting, and perfecting water treatment systems for families and homeowners.
This site is the result of that real-world experience. You won’t find sponsored content or marketing fluff here. Just honest, field-tested water treatment guides to help you make the right decision for your home and family, without the sales pressure.


Solve Your Water Problem

Hard Water
Whether you’re new to hard water or looking to maintain your system, our guides cover every step of the journey.

Iron & Manganese

Rotten Egg Smell
Bacteria & Viruses

Sediment & Turbidity

Lead & Heavy Metals

Acidic Water (Low pH)

Chemicals & Nitrates

More problems and solutions
Your All-in-One Resource: Comprehensive Water Treatment Guides
Navigating the world of water treatment can be confusing. From decoding a water test report to choosing between a water softener and an iron filter, the technical details can feel overwhelming. This resource was built to cut through the noise.
Whether you’re on well water or city supply, we provide clear, step-by-step water treatment guides to diagnose and solve your specific issues. We cover everything from removing common nuisances like hardness, iron stains, and rotten-egg smells, to tackling serious contaminants like lead, bacteria, and forever chemicals (PFAS). Our mission is to give you the unbiased, expert knowledge you need to ensure your family’s water is pure, safe, and clean.